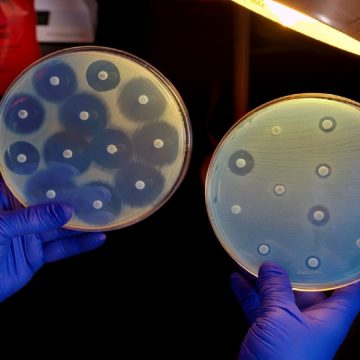

Saúde
Nem sempre o número de transplantes acompanha o número de doadores. Neste sentido, alguns dados da ABTO (Associação Brasileira de Transplante de Órgãos) e do SNT (Sistema Nacional de Transplante) do Ministério da Saúde diferem em relação à atual situação dos transplantes de órgãos no Brasil. No lançamento nacional de Doação de Órgãos na Casa […]
Por Roberta Massa | 27.09.2016

Saúde
Meu pai tem uma relação de muita confiança com as farmácias e com alguns farmacêuticos em especial. Não com as farmácias das grandes redes, daquelas que mais parecem um supermercado, mas com aquelas pequenas, de bairro. Na infância, a farmácia de referência era a do seu Domingos, que ficava ma avenida Dom Pedro, em Ribeirão […]
Por Roberta Massa | 27.09.2016

Saúde
Após perder dois dos trigêmeos, casal teve de dar aval para tratamento de risco que utiliza equipamento externo para conduzir o sangue. Parecia uma tosse inofensiva, dessas comuns nos primeiros anos de vida de qualquer criança. O quadro, porém, não era tão simples quanto aparentava. Davi, então com 1 ano e 4 meses, havia sido […]
Por Roberta Massa | 26.09.2016

Saúde
Confira os programas de prevenção oferecidos pelos hospitais Sírio-Libanês e Oswaldo Cruz, em São Paulo. 29/9 – Dia Mundial do Coração Para pessoas na faixa dos 45 – 60 anos, fumantes, mulheres na menopausa e pessoas que tenham alto consumo de álcool. Nova forma de diagnóstico: Heart Team, a metodologia consiste em descentralizar as decisões de […]
Por Roberta Massa | 26.09.2016

Saúde
O trabalho de prevenção e foco na cultura da “pele íntegra” trouxeram ao VITA Curitiba e ao VITA Batel mais um reconhecimento importante: a Certificação Diamante Prime em Prevenção de Lesões de Pele do Grupo 3M. O programa educacional idealizado pela multinacional conta com uma série de critérios a fim de estimular a prevenção de […]
Por Roberta Massa | 23.09.2016

Saúde
Líderes do mundo inteiro pediram nesta quarta-feira (21) uma mobilização de governos, médicos, laboratórios e consumidores para frear a ameaça crescente das chamadas superbactérias, resistentes a todos os antibióticos conhecidos, que geram um grande número de doenças cada vez mais difíceis de curar. “A resistência antimicrobiana representa uma ameaça fundamental de longo prazo para a […]
Por Roberta Massa | 23.09.2016